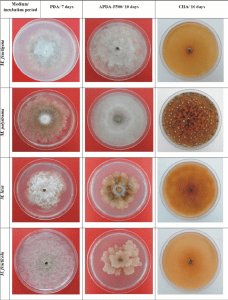
Monilioza rozne kmene

HMYZÍ TRUS jako HNOJIVO NA ŠVESTKY
Choroby švestek
Obsah
Švestka


Švestka domácí ( Prunus domestica ) je listnatý strom z rodu Prunus . Poměrně dobře snáší zimu či pozdní jarní mrazíky , proto se vs oblibou pěstuje iv chladnějších klimatických podmínkách Její plody, švestky, patří mezi oblíbené peckové ovoce, které si mnozí z nás pěstují ve svých zahradách či ovocných sadech. Jelikož jsou velmi chutné, kromě konzumace v syrovém stavu jsou vhodné i výrobu nejrůznějších dobrot v kuchyni, k zavařování, mrazení, výrobě marmelek, či pálení slivovice, ale i sušení. Švestky jsou skutečný zázrak přírody. Čistí krev, snižují vysoký krevní tlak i vysoký cholesterol. Pomáhají při revmatu či onemocněních jater a ledvin.

Léčivé účinky švestek lidé znali již před více než 2 000 lety . První kultivovaný strom švestky byl vypěstován v Damašku . Odtud se pěstování švestek rozšířilo ik nám, do Evropy. Jeho léčivé účinky znali již staří Římané. V současnosti se švestky staly součástí mnoha národních kuchyní a patří mezi nejoblíbenější druhy ovoce.
Choroby švestek

Švestky – radost z jejich pěstování a jejich užitku nám mohou překazit nemoci švestek, kterými mohou trpět a způsobit jak oslabení stromu, snížení či zničení úrody, tak i odumření části či celého stromu. To jsou nemilé záležitosti. Jaké tedy známe nemoci švestek? Není jich málo. U nás se vyskytují následující: šárka švestek , monilióza peckovin , klasterosporióza , virus zakrslosti švestek, virus nekrotické kroužkovitosti švestek, drobná skvrnitost listů švestek, sklípek purpurový, rez švestek , bakteriální rakovina a suchá skvrnitost listů.Mnohé z těchto onemocnění jsou si podobné ať už názvem nebo projevy. Je dobré zorientovat se v této problematice a nejlépe snažit se jim předcházet.
Šárka švestek
Šárka švestek ( Plum pox virus ) je velmi vážné virové onemocnění peckovin, které patří do rodu Potyvirus . Jeho hlavními přenašeči jsou druhy mšic škodících na peckovinách a infikovaný rostlinný materiál přenášený do nových lokalit. Virus šárky nepředstavuje nebezpečí pro spotřebitele, ale může zničit úrodu ovoce tím, že způsobuje jejich předčasné opadnutí, kyselost a deformace. Symptomy napadení lze sledovat na listech, plodech a výjimečně i peckách.
Šárka švestek obecně způsobuje na listech světle zelené až žlutozelené skvrny nepravidelného tvaru a různé velikosti, bez ostrého ohraničení. Jsou patrné od května. Na plodech se projevy ukazují na začátku jejich zrání. Vytváří se nich skvrnité kresby, které se postupně přepadávají. Dužina na místě propadlin je červenohnědá, nekrotická a pevně drží u pecky. V napadených plodech je snížen obsah cukru a kyselin, jsou tak bezcenné a dochází k jejich předčasnému opadávání.
Hostiteli šarky mohou být všechny švestkoviny, meruňka, broskev, mandle, trnka, višeň plstnatá. Projevy tohoto virového onemocnění jsou proto velmi variabilní a liší se v závislosti na druhu hostitele, jeho odrůdě a kmene viru. V současnosti je popsáno devět kmenů viru šárky švestek, které se liší jak agresivitou, tak symptomatickými projevy. Obecně platí, že nejcitlivější jsou mladé výsadby ovocných druhů.
Přítomnost šárky švestek může zesílit účinky jiných endemických virů infikujících různé druhy rodu Prunus. Virus výrazně zpomaluje růst ovocných dřevin a snižuje jejich mrazuvzdornost.

Šárka sliviek – Príznaky na plodoch slivky japonskej cv. Červená krásavica. Choré ovocie sa porovnáva s dvoma zdravými plodmi vľavo
Zdroj fotiek: www.uksup.sk

Šárka sliviek – Príznaky infekcie na listoch slivky cv. Brompton, ukazuje žltkasté krúžky
Zdroj fotiek: www.uksup.sk
Monilióza peckovin
Monilióza peckovin ( Monilinia laxa / Monilinia fructigena ) je v našich končinách se často vyskytující onemocnění, které dokáže zničit převážnou část květin a větviček. Ještě více ničivé je napadení dozrávajících a zralých plodů. Takové plody jsou zcela znehodnoceny. Napadené květiny a mladé plody hnědnou a zasychají. Listy, mladé výhonky a větvičky vadnou a schnou, přičemž se často na postižených místech objevuje klejotok. Napadené plody buď opadají, nebo tvz. mumifikují a zůstanou v koruně stromu. K jejich napadení dochází nejčastěji při jejich poranění.
Houba Monilióza přezimuje jako podhoubí v pletivu napadených rostlinných částí – napadené větvičky či mumifokované plody, které zůstaly na stromě. K infikování moniliózou dochází většinou za chladného a vlhkého počasí.

Monilióza peckovin- mumifikované plody švestky se zdravým plodem
Zdroj: M.Hluchý, P.Ackermann, M.Zacharda, Z.Laštůvka, M.Bagar, E.Jetmarová, G.Vanek: Ochrana ovocných dřevin a révy vinné v ekologické produkci. Biocont Laboratory, Modřice

Monilióza peckovin- Monilinia laxa vlevo a Monilinia fructigena vpravo
Zdroj: M.Hluchý, P.Ackermann, M.Zacharda, Z.Laštůvka, M.Bagar, E.Jetmarová, G.Vanek: Ochrana ovocných dřevin a révy vinné v ekologické produkci. Biocont Laboratory, Modřice

Monilióza peckovin – na mladé vetvičce
Zdroj: Shuhrataxmedov – vlastné dielo, CC BY-SA 3.0, https://commons.wikimedia.org/w/index.php?curid=19462852
Klasterosporióza (dírkovitost listů a skvrnitost plodů)
Klasterosporióza ( Clasterosporium carpophilum) – je houbovité onemocnění. Příznaky klastrosporiózy se na listech projevují brzy na jaře, když vypučí listy, ve formě kulatých, několik milimetrů velkých (asi 5 mm), oranžových skvrn. Ty jsou později ostře ohraničeny a jejich barva přechází do hnědé. Obranná reakce hostitele v místě infekce vytvoří oddělovací vrstvu, aby nedocházelo k pronikání toxinů do zdravých pletiv a následně takto oddělené skvrny vypadávají z čepele listů. Od tohoto je odvozen název děrovitost listů.
Druhý příznak houbového onemocnění klasterosporiózy jsou drobné skvrny na plodech – často doprovázené klejotokem. Tmavé, hnědočerné skvrny přecházejí do korkovitosti dužiny.
Na letorostech a mladých větvičkách se vyskytují hrbolky, promáčknutí a různé zduřeniny hnědočervené barvy. Jejich povrch bývá popraskaný, zvrásněný a osídlují jej saprofytické houby. Následkem napadení je snížení intenzity fotosyntézy, snížení násad květních poupat a tím i plodů. Letorosty a větvičky zaostávají v růstu. Plody se znehodnocují, za vlhka hnijí, za sucha se scvrkávají. Vytvořené rány se stávají vstupní branou pro jiná onemocnění. U mladých stromků může dojít k jejich odumření.
Virus zakrslosti švestek
Virus zakrslosti švestek (Prune dwarf virus; PDV) – způsobuje odumírání pupenů a obrostu, oslabení růstu a následné snížení úrody. Objevuje se na čepelích listů jako světle zelené, různě velké kruhy, skvrny, pruhy či kresby. Takto napadená místa od středu nekrotizují a listy se deformují. Způsobuje nápadnou zakrnělost listů. Intenzita a projevy tohoto onemocnění se liší v závislosti na hostiteli, kmenu viru a počasí. Při nižších teplotách jsou projevy viditelnější. Virus napadá jak švestky, tak i třešně, višně, meruňky, broskve a další příbuzné dřeviny. Přenáší se vegetativně skrz rub, očko, vegetativní odnož au některých druhů i pylem a semeny – zejména višeň a třešeň.

Virus zakrslosti švestek – napadený list
Zdroj: M.Hluchý, P.Ackermann, M.Zacharda, Z.Laštůvka, M.Bagar, E.Jetmarová, G.Vanek: Ochrana ovocných dřevin a révy vinné v ekologické produkci. Biocont Laboratory, Modřice
Virus nekrotické kroužkovitosti švestkovin

Virus zakrslosti švestek – napadený list
Zdroj: M.Hluchý, P.Ackermann, M.Zacharda, Z.Laštůvka, M.Bagar, E.Jetmarová, G.Vanek: Ochrana ovocných dřevin a révy vinné v ekologické produkci. Biocont Laboratory, Modřice
Virus nekrotické kroužkovitosti švestek (Prunus necrotic ringspot virus; PNRSV, Aplle mosaic virus; ApMV) – vytváří typické příznaky na listech, které se vyvinuly na jaře a začátkem léta, kdy jsou nižší teploty. Na listových čepelích jsou světle zelené až jasně žluté ostře ohraničené skvrny, pruhy a kresby. Pruhy obvykle vytvářejí tzv. pruhy. dubolisté kresby. Stromy při silném napadení mají výrazně menší listy, kratší přírůstky a dávají menší úrodu. Tento virus se přenáší jako pylem, semeny i vegetativním množením očkem, rubem a vegetativní odnoží.
Drobná skvrnitost listů švestkovin
Drobná skvrnitost listů švestkovin (Phyllosticta prunicola)– se šíří především během vlhkého deštivého počasí. Většinou napadá listy, ale může napadnout i plody a výjimečně i letorosty. Obvykle se na listech objeví drobné, kulaté, červenofialové až fialově šedé skvrny, které jsou často lemovány tmavším okrajem o průměru 1 až 2 mm. Uprostřed skvrn se vytvářejí plodničky, které tvoří tmavé body. Tyto skvrny od prostředku zasychají a vypadávají. Listy, které jsou silně postiženy předčasně opadávají. Na plodech se při napadení tvoří pravidelné malé šedozelené skvrny, častokrát lemované červenofialovým okrajem a postižené části plodu postupně korkovatí. Skvrny drobné skvrnitosti listů švestkovin jsou velmi podobné suché skvrnitosti listů a přesné určení diagnózy vyžaduje mikroskopické vyšetření.

Drobná skvrnitost listů švestkovin na listech
Zdroj: M.Hluchý, P.Ackermann, M.Zacharda, Z.Laštůvka, M.Bagar, E.Jetmarová, G.Vanek: Ochrana ovocných dřevin a révy vinné v ekologické produkci. Biocont Laboratory, Modřice
Pevníkovec purpurový

Pevníkovec purpurový – spôsobuje strieborné listy
Zdroj: M.Hluchý, P.Ackermann, M.Zacharda, Z.Laštůvka, M.Bagar, E.Jetmarová, G.Vanek: Ochrana ovocných dřevin a révy vinné v ekologické produkci. Biocont Laboratory, Modřice
Pevníkovec purpurový (Chondrostereum purpureum) – je tzv. dřevokazná houba, která roste během celého roku, ale nejvíce od podzimu do jara. Kromě jehličnatých stromů napadá také ovocné stromy a keře, především švestky. Způsobuje bílou hnilobu dřeva, přičemž postižena může být jen část stromu, ale také celý strom. Kmen napadené dřeviny se zbarvuje do hnědočervené barvy a listy jsou stříbřitě lesklé. Napadené větve či stromy chřadnou a může odumírat. Na odumřelém dřevě vyrůstají červené až fialové, později hnědé plodnice této houby. Infekce vznikají na čerstvých ranách stromů a keřů, většinou do 1 týdne od poranění. Nejčastěji k tomu dochází v období jara nebo podzimu. Toxické látky vylučované do listů způsobuje jejich stříbřité zbarvení.

Pevníkovec purpurový ve francouzské zahradě v Massy. Tato houba způsobuje ‚Stříbrný list‘.
Zdroj: https://en.wikipedia.org Autor: Strobilomyces
Rez švestková
Reza švestková (Tranzschelia pruni-spinosae, Tranzschelia discolor)– je onemocnění, jehož průvodním projevem je náhlý opadnutí napadených dopisů. Kromě švestky domácí jsou hostitelskými rostlinami jsou meruňka obecná, trnka obecná, mandle obecná, střemcha obecná a větrnice jiskerníkovitá. Období přezimování na mezihostiteli (větrnice jiskerníkovitá) je ve stádiu mycelia. V oblastech s teplejším klimatem může rez švestek přezimovat i na neopadaných listech a může přerůst až do větviček stromů, na kterých přezimuje. Typické příznaky napadení švestek rzí jsou nafialovělé nebo nažloutlé skvrny, které se objevují na vrchní straně listů, často prodloužené ve směru žilek. Skvrny jsou nepravidelně rozmístěné, s různými tvary a na jejich spodní straně se v místě skvrn setkáváme s drobnými, kulatými a prášivými hromádkami uredospor, které jsou skořicově hnědé barvy. Při silné infekci postupně dochází k předčasnému opadu listů. Od konce srpna na spodních stranách listů lze pozorovat černohnědá ložiska, která jsou v teleutosporovém stadiu.

Hrdza sliviek – vrchná strana listu – Drobné, žlté, nepravidelné škvrny na vrchnej strane listov
Zdroj: www.ecophyta.sk

Hrdza sliviek – spodná strana listu – Drobné, okrúhle, prášivé kôpky spór huby
Zdroj: www.ecophyta.sk

Hrdza sliviek na listoch
Zdroj: M.Hluchý, P.Ackermann, M.Zacharda, Z.Laštůvka, M.Bagar, E.Jetmarová, G.Vanek: Ochrana ovocných dřevin a révy vinné v ekologické produkci. Biocont Laboratory, Modřice
Grmaník švestkový
Grmaník švestkový (Taphrina pruni / Taphrina insititiae)– v našich podmínkách se vyskytuje většinou ve vyšších oblastech, kde je chladněji. Kromě švestky napadá i na meruňky a třešně. Napadené plody jsou bez chuti, nedozrávají a mají nízkou kvalitu. V porování se zdravými plody po odkvětu dochází u napadených plodů ke zvětšování a prodlužování. Barva plodů švestek je zelená až žlutozelená, dužina je tvrdá, bez šťávy a chuti, přičemž plody jsou pokryty bělavým povlakem. Napadené plody od července opadávají. Nevytváří se v nich pecka a již nejsou použitelné, ani se nedají dále zpracovat. Pro grmaníka švestkového je typická deformace plodů, jejich abnormální zvětšení, prodloužení a prolíčení. Často bývá napadena pouze část plodu a vytvářejí se tak nepravidelné nádory na nich. Zdeformované plody se postupně scvrkávají a hnědnou.
Napadení grmaníkom švestkovým se může vyskytnout i na letorostech stromů, které následně hrubnou, krpatí a zkrucují se. Při silném napadení letorostů dochází k jejich postupnému usychání. Grmaník švestkový přezimuje myceliem nebo blastospórami v napadených větvích, odkud přerůstá do listů a pupenů. Za vlhkého a chladného počasí během časného jara přerůstá grmaník do mladých plodů a infikuje je. Z infikovaných plodů se ve druhé polovině července rozšiřují pomocí větru.

Nemoci švestek – Grmaník švestkový na švestce
Zdroj: M.Hluchý, P.Ackermann, M.Zacharda, Z.Laštůvka, M.Bagar, E.Jetmarová, G.Vanek: Ochrana ovocných dřevin a révy vinné v ekologické produkci. Biocont Laboratory, Modřice

Nemoci švestek – Grmaník švestkový na švestce
Zdroj: M.Hluchý, P.Ackermann, M.Zacharda, Z.Laštůvka, M.Bagar, E.Jetmarová, G.Vanek: Ochrana ovocných dřevin a révy vinné v ekologické produkci. Biocont Laboratory, Modřice
Evropská žloutenka peckovin
Evropská žloutenka peckovin (Apricot chlorotic leafroll phytoplasma, syn. European stone fruit phytoplasma – ESFY) – je řazena k fytoplazmám, které jsou známé tím, že nejsou ohraničeny buněčnou stěnou a nelze je kultivovat na živných médiích, tak jak je to možné. běžných bakteriích.
Hostitelský okruh je relativně úzký, jelikož fytoplazma napadá především druhy rodu Prunus. K přenosu, bez lidského přičinění, potřebuje fytoplazma bodavě savý hmyz, ve kterém dokáže fytoplazma prožívat a množit se. Při přijímání potravy se dostává do další hostitelské rostliny. Dosud jedinými známými vektory této fytoplasmy jsou méra Cacopsylla pruni, který preferuje rostliny z rodu Prunus a cikádka Fieberiella florii. Nejideálnějším časem pro pozorování příznaků je období před kvetením hostitelů a koncem léta. Symptomy infekce se liší v závislosti na druhu infikovaného hostitele.
Příznaky napadení na švestce obyčejné je proliferace větví, malý počet listů, mírná chloróza a prosychání koruny. Obvykle následuje postupné odumírání větví či odumírání celého napadeného stromu, a to v průběhu zimního nebo jarního období. Onemocnění je charakteristické svým rychlým postupem. Broskve, švestky a třešně však nepodléhají odumírání takovou rychlostí jako meruňky.
Zdroj: www.uksup.sk
Červená skvrnitost listů švestek

Červená skvrnitost listů na švestce
Zdroj: M.Hluchý, P.Ackermann, M.Zacharda, Z.Laštůvka, M.Bagar, E.Jetmarová, G.Vanek: Ochrana ovocných dřevin a révy vinné v ekologické produkci. Biocont Laboratory, Modřice
Červená skvrnitost listů švestek (Polystigma rubrum) – je houbovité onemocnění, které napadá švestky a trnky. Projevy onemocnění u švestek se liší podle odrůdy švestek. Červená skvrnitost na listech švestek začíná žlutozelenými, později cihlově červenými, kulatými, ohraničenými a vypouklými kožovitými skvrnami o velikosti 0,5 až 1cm. Ty ke konci vegetace tmavnou a od svého středu černí. Při silném napadení se listy deformují, usychají a předčasně opadávají. Na takto opadlých listech houba přezimuje a krátce po odkvětu hostitelských rostlin se vzdušnými proudy askospory houby přenášejí na nové mladé listy. Rozmnožování a přenos askospór je během teplého a deštivého počasí. Toto infekční období trvá obvykle 3 až 5 týdnů.

Červená skvrnitost listů – silně napadená švestka
Zdroj: M.Hluchý, P.Ackermann, M.Zacharda, Z.Laštůvka, M.Bagar, E.Jetmarová, G.Vanek: Ochrana ovocných dřevin a révy vinné v ekologické produkci. Biocont Laboratory, Modřice
Abiotická nekróza listů švestky
Abiotická nekróza listů švestky – se projevuje náhlým zaschnutím okrajů, částí nebo celých listů. Takto napadené části jsou světle hnědé a ostře ohraničené od zdravých zelených částí listů. Nejčastěji bývají postiženy na stromě části koruny, které jsou vystaveny přetrvávajícímu větru. Ve výjimečných případech může dojít k poškození celé koruny stromu. Tento stav není vyvolán houbovým, bakteriálním onemocněním ani jako následek napadení škůdcem. Způsobuje jej náhlá nadměrná ztráta vody z pletiv listů, kdy po dlouhotrvajícím období sucha nastane vydatný déšť. Ten způsobí, že listy přijmou do sebe hodně vody a následný teplý vítr je příliš vysuší. Ochranou proti abiotické nekróze listů je proto zajištění optimálního fyziologického stavu rostliny s pravidelnou přiměřenou závlahou.

Abiotická nekróza listů na švestce
Zdroj: M.Hluchý, P.Ackermann, M.Zacharda, Z.Laštůvka, M.Bagar, E.Jetmarová, G.Vanek: Ochrana ovocných dřevin a révy vinné v ekologické produkci. Biocont Laboratory, Modřice
Bakteriální rakovina
Bakteriální rakovina (Pseudomonas syringae pv. syringae, Valsa cincta a Valsa leucostoma) – postihuje všechny druhy pěstovaných peckovin. Vytváří na větvích a kmenech stromů tmavě zabarvená místa, která se mírně propadávají a postupně nekrotizují. Objevují se nejčastěji na místě větvení nebo v okolí odumřelých větviček či poranění po řezu. Části stromu nad takovou nekrotizující skvrnou vadnou a usychají. Při chronickém projevu tvoří menší, žlutozelené listy a kratší přírůstky. Na postižených místech se často vyskytuje silný klejotok. Bakteriální rakovina může způsobit odumření celého stromu. K infekcím dochází v období podzimu (při opadu listů) a jara (před a při rašení), zvláště za deštivého počasí.

Nemoci švestek – Bakteriální rakovina
Zdroj: M.Hluchý, P.Ackermann, M.Zacharda, Z.Laštůvka, M.Bagar, E.Jetmarová, G.Vanek: Ochrana ovocných dřevin a révy vinné v ekologické produkci. Biocont Laboratory, Modřice
Suchá skvrnitost listů
Suchá skvrnitost listů (Stigmina carpophila) – je vážné houbovité onemocnění. Na listech jsou patrné kulaté různě velké žlutozelené či červenofialové skvrny, které mají často výrazné olemování. Při jejich větším počtu splývají do jednoho celku. Později tmavnou a mezi zdravým a napadeným pletivem listu se vytváří oddělovací vrstva, což způsobí, že uschlá pletiva vypadávají. Pokud jsou v listech napadeny vodivé svazky, listy žloutnou, červenají a předčasně opadávají.
Suchá skvrnitost způsobuje i to, že na jaře neraší očka na jednoletých plodných větvičkách a kolem oček vznikají 3-10 mm velké nekrotické oválné skvrny. Následně na odumřelých částech vytéká klejotok. Při silném napadení zasychají větvičky. Při napadení mladých plodů se nejprve objeví drobné červenofialové skvrny, které se postupně zvětšují a od středu šednou. Jejich okraj zůstává olemován na červenofialově. Později se na plodech objevují skvrny různých velikostí s tmavým nebo světlým olemováním. Při jejich větším počtu splynou, plody se zdeformují a praskají.
Projevy napadení se liší podle jednotlivých odrůd. Houba přezimuje v napadených pupenech a větvičkách. Za vlhkého počasí se může houba šířit v průběhu celé vegetace.

Suchá skvrnitost listů – detail na listu
Zdroj: M.Hluchý, P.Ackermann, M.Zacharda, Z.Laštůvka, M.Bagar, E.Jetmarová, G.Vanek: Ochrana ovocných dřevin a révy vinné v ekologické produkci. Biocont Laboratory, Modřice

Suchá skvrnitost listů
Zdroj: M.Hluchý, P.Ackermann, M.Zacharda, Z.Laštůvka, M.Bagar, E.Jetmarová, G.Vanek: Ochrana ovocných dřevin a révy vinné v ekologické produkci. Biocont Laboratory, Modřice
Jak na nemoci švestek
Jak na nemoci švestek? Na výběr jsou jak přírodní, tak chemická řešení. Určitě je jednodušší a zároveň i levnější napadení předcházet budováním zdravé silné imunity rostlin a vytvořením optimálních podmínek pro jejich pěstování.
Aplikace Hnojíku je možná jak posypem , zálivkou , tak i postřikem . Zálivka a postřik mají rychlejší nástup účinku. Účinek posypu má delší trvání. Ideální je jejich kombinace. Jak na to? Jak použít hnojivo Hnojik.CZ? Způsoby aplikace i dávkování se dozvíte v následujícím odkazu.

Zdroje informácí
- M.Hluchý, P.Ackermann, M.Zacharda, Z.Laštůvka, M.Bagar, E.Jetmarová, G.Vanek: Ochrana ovocných dřevin a révy vinné v ekologické produkci. Biocont Laboratory, Modřice
- www.uksup.sk
- www.agromanual.cz
- zahradaweb.cz
- www.nahuby.sk
- wikipedia.org
- botany.cz
- www.ecophyta.sk
- www.biolib.cz
- www.ecophyta.sk
- pixabay.com